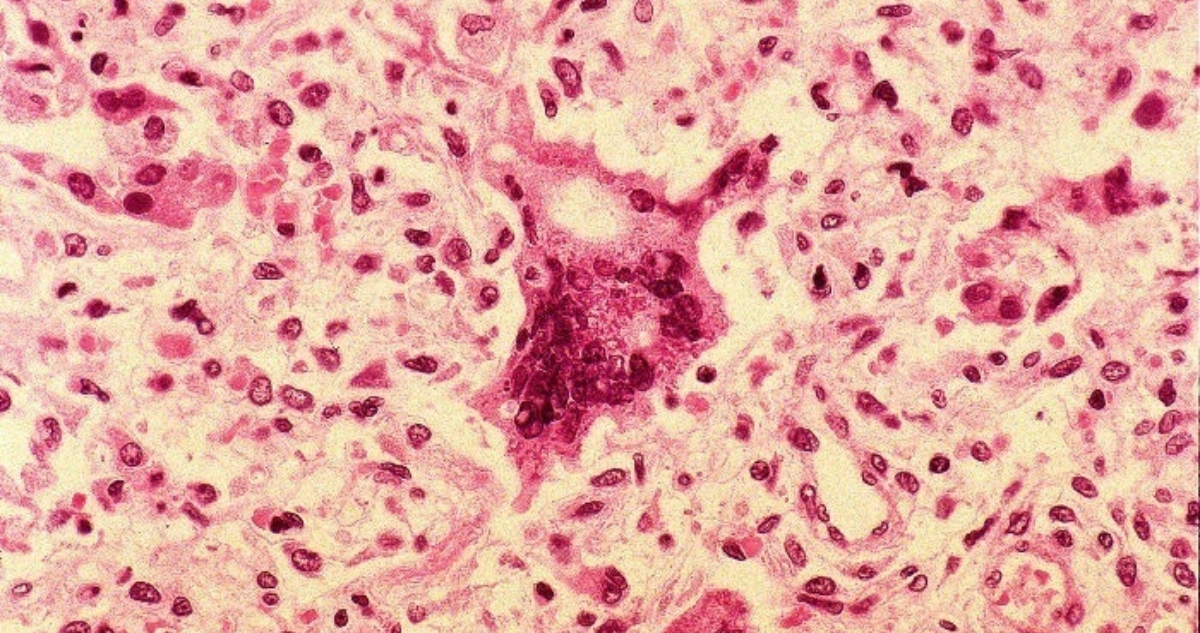
sarampión

David Kershenobich informó que hay 362 casos de sarampión en México. Ante dicha situación, se activó un cerco sanitario en Chihuahua y se reforzó la vacunación.
Ciudad de México, 15 de abril (SinEmbargo).- El titular de la Secretaría de Salud (SSa), David Kershenobich Stalnikowitz, informó este día que México acumula 362 casos confirmados de sarampión, de los cuales 347 ocurrieron en el estado de Chihuahua.
Durante su participación en la conferencia matutina de la Presidenta Claudia Sheinbaum, Kershenobich señaló que se implementó un cerco vacunal en la entidad para contener el brote, además de que se reforzó la Campaña Nacional de Vacunación.
Otros estados con presencia del virus son Campeche, Oaxaca, Sonora —con cuatro casos cada uno—; así como Sinaloa, Querétaro y Zacatecas, donde se ha confirmado un caso por entidad.
Kershenobich explicó que los casos en estas regiones están relacionados con desplazamientos a zonas con contagios activos, como Chihuahua, por lo que también se realizaron acciones de contención en esos puntos.
#Sarampión | Si al regresar de viaje presentas algún signo o síntoma, solicita atención medica inmediata e informa al personal de salud a que sitio viajaste.
📌Ingresa a: https://t.co/6pTj0xjjhF#PrevenirEsSalud pic.twitter.com/thjYqyVrvA— Secretaría de Salud del Estado de México (@SaludEdomex) April 14, 2025
“En todos estos sitios hemos logrado demostrar que tienen sarampión y hemos contenido los casos alrededor de donde se han diagnosticado, pero a la vez se ha implementado el programa de prevención en forma muy activa”, aseguró el Secretario de Salud.
De los casos registrados en Chihuahua, todos corresponden a personas que no contaban con la vacuna contra el virus, lo que refuerza la urgencia de completar los esquemas de inmunización.
“En Chihuahua ha habido casos en población que no estaba vacunada y ese es un aspecto muy importante a tomar en cuenta”, puntualizó Kershenobich.
El brote ya cobró una vida. Se trata de un hombre de 31 años, originario de Ciudad Juárez, quien además presentaba enfermedades crónicas como daño renal y diabetes.
El sarampión es una enfermedad vírica muy contagiosa que afecta a niños y adultos no vacunados.
Provoca fiebre alta, erupción en todo el cuerpo y tos. En casos graves, puede causar neumonía, daños cerebrales permanentes, sordera o incluso la muerte.#Vacúnate
Vía @opsoms pic.twitter.com/W5wOgRNVUN
— ONU México (@ONUMX) March 25, 2024
“Ha habido una defunción en un paciente que no tenía nada más sarampión, sino que tenía tenía daño renal, daño orgánico y comorbilidades como diabetes, además no estaba vacunado contra el virus del sarampión”, detalló el titular de Salud.
Además del fallecido, cinco personas con sarampión fueron hospitalizadas por complicaciones como neumonía, mientras que un caso presentó encefalitis. Esta última persona ya fue dada de alta.
Entre enero y marzo, las autoridades han aplicado 715 mil 277 dosis de la vacuna contra sarampión y rubéola en todo el país como parte de las medidas de prevención. El Secretario reiteró la importancia de reforzar la inmunización, sobre todo en temporada vacacional, cuando aumenta la movilidad hacia zonas donde circula el virus.
Del 26 de abril al 3 de mayo se realizará una jornada nacional de vacunación enfocada en reforzar la cobertura en grupos vulnerables. Las dosis están dirigidas principalmente a niñas y niños de 1 a 9 años, adolescentes y adultos de 10 a 39; así como a personal de salud que no esté inmunizado. Además, Kershenobich hizo un llamado a quienes viajan a Estados Unidos u otras regiones con brotes activos a que se vacunen antes de salir del país.
“Insistimos en la necesidad de vacunación”, expresó el funcionario al destacar que la mayoría de los contagios se han dado entre personas sin esquema completo.
Como parte del programa Salud Casa por Casa, Ariadna Montiel, Secretaria de Bienestar, explicó que personal médico ha visitado ya a 8.2 millones de adultos mayores y personas con discapacidad. Las brigadas continuarán hasta alcanzar a más de 13 millones de beneficiarios, quienes también recibirán atención médica básica y valoración de su estado general de salud.
El sarampión es una enfermedad extremadamente contagiosa, por lo que es importante permanecer atento a los síntomas.
Vacúnate contra el sarampión, protégete y evita contagios.#PrevenirEsSalud pic.twitter.com/BOdPIkNpEC— Secretaría de Salud del Estado de México (@SaludEdomex) March 5, 2024
Para mejorar la cobertura en zonas remotas, el Gobierno activará un nuevo modelo de brigadas móviles, con médicos, enfermeras y técnicos que acudirán a comunidades de difícil acceso. Por su parte, el titular del Instituto Mexicano del Seguro Social (IMSS), Zoé Robledo, anunció mejoras en infraestructura médica, incluyendo la sustitución de equipos electromecánicos, torres de enfriamiento, elevadores y sistemas de aire acondicionado.
También se actualizaron instalaciones en hospitales y centros de investigación como parte del censo diagnóstico que se realizó en 2021. Finalmente, Martí Batres, director del Instituto de Seguridad y Servicios Sociales de los Trabajadores del Estado (ISSSTE), informó que siete mil 950 trabajadores han solicitado la ampliación voluntaria de su jornada laboral de seis a ocho horas y la convocatoria sigue abierta hasta el 25 de abril.